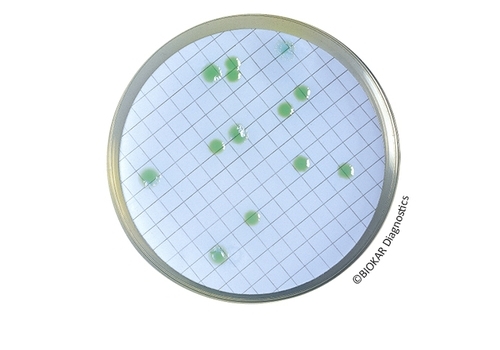

Pseudomonas
Pseudomonas are ubiquitous. They can be found in water and soil as well as on and in plants and animals. Some representatives of these aerobic, gram-negative bacteria can be hazardous for humans. Tests of drinking, mineral, table and bathing water for Pseudomonas is thus prescribed by law.

Acetamide Broth
Acetamıde Broth Acetamide broth constitutes one of the confirmation media (in association with..
More
CFC Agar
CFC Agar CFC Agar is a selective medium for the enumeration of Pseudomonas spp. that frequently..
More
CN Agar For PSEUDOMONAS
CN Agar For Pseudomonas CN Agar for Pseudomonas is a selective medium for the isolation and..
More
Glucose Agar
Glucose Agar Glucose agar allows the demonstration of glucose fermentation (with or without gas..
More
King B Agar
King B Agar King B agar allows the production of fluoresceine (or pyoverdin), a yellow-green..
More
Penicillin And Pimaricin Agar
Penicillin And Pimaricin Agar Penicillin and Pimaricin Agar (PPA) is a selective medium for the..
More
Rhapsody Agar®
Rhapsody Agar® RHAPSODY Agar® is a selective medium used for the enumeration of..
More